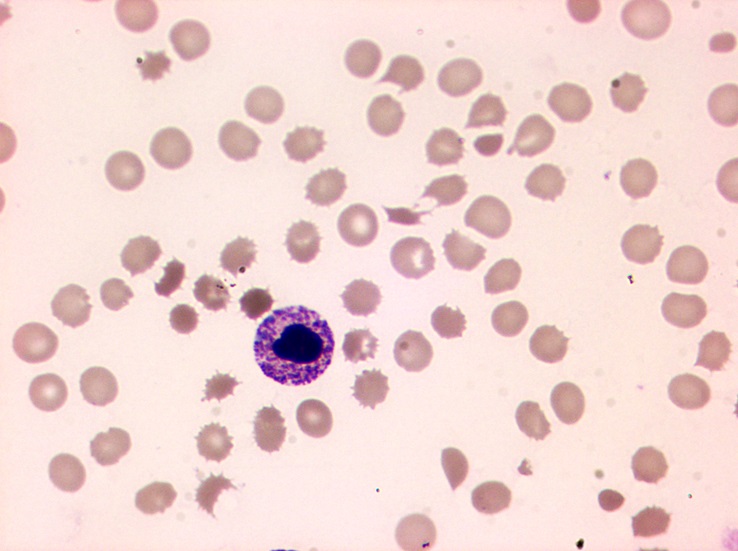
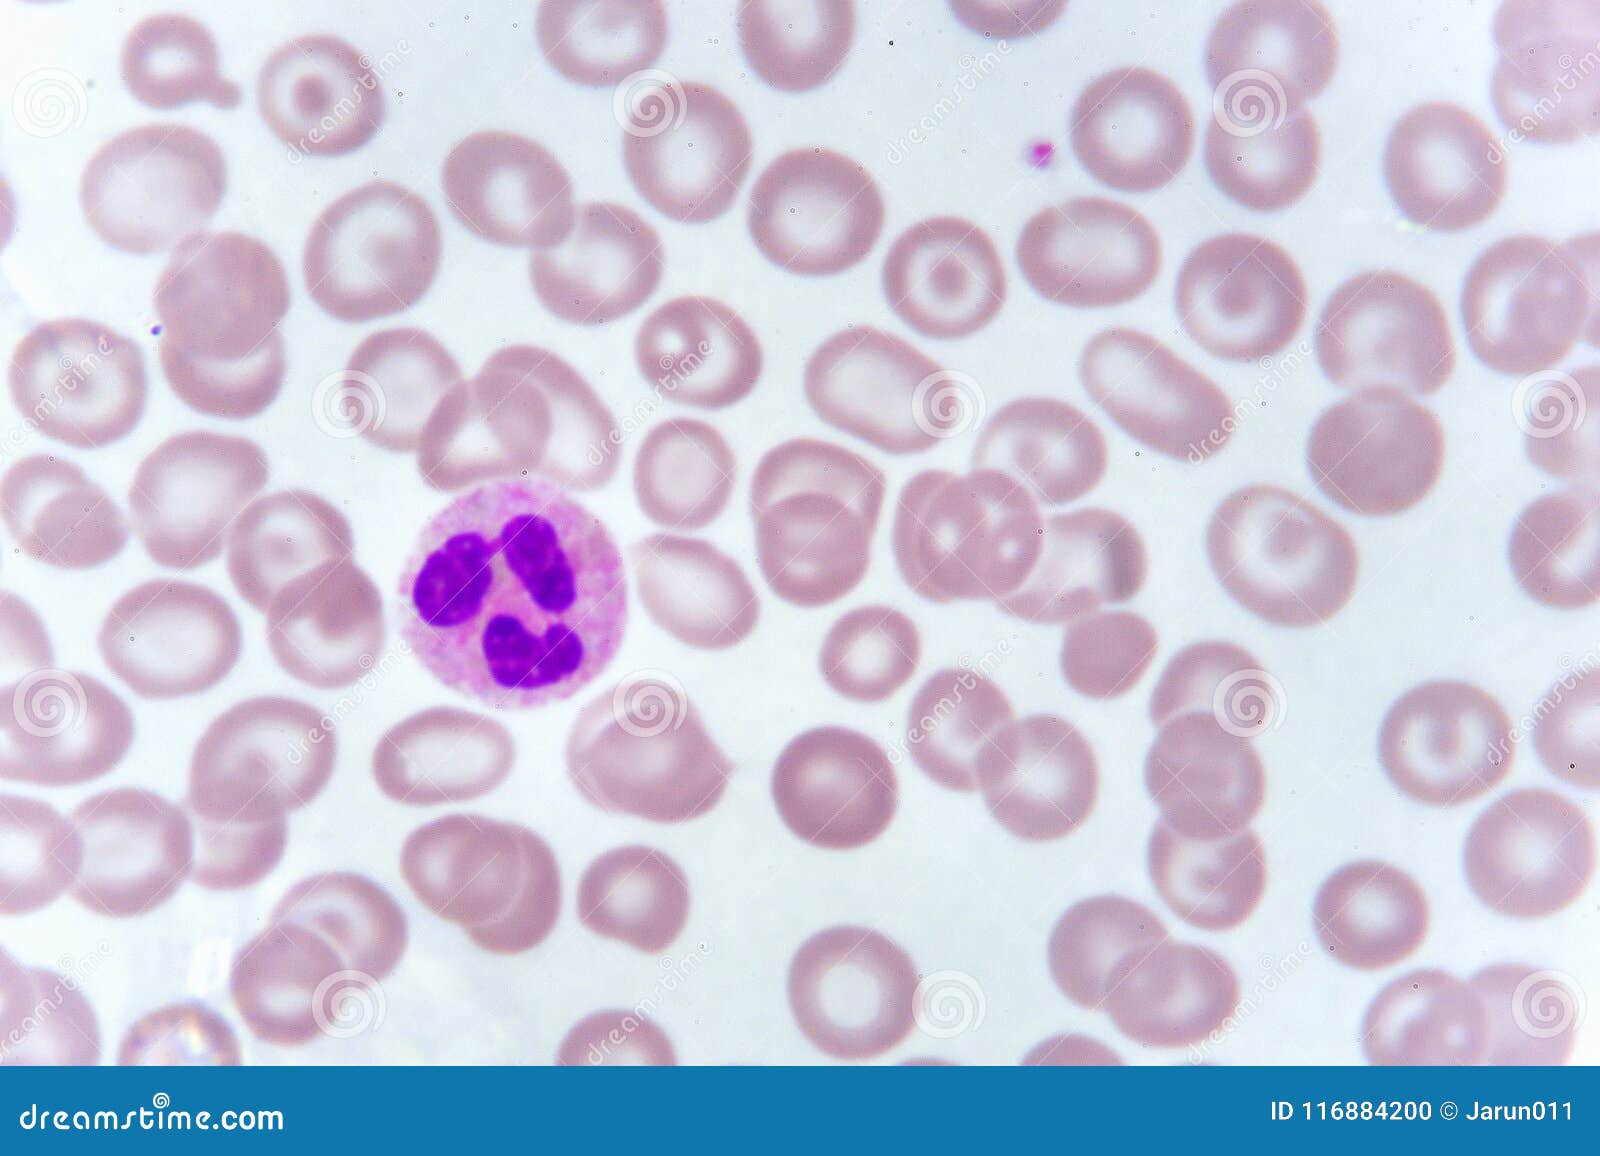
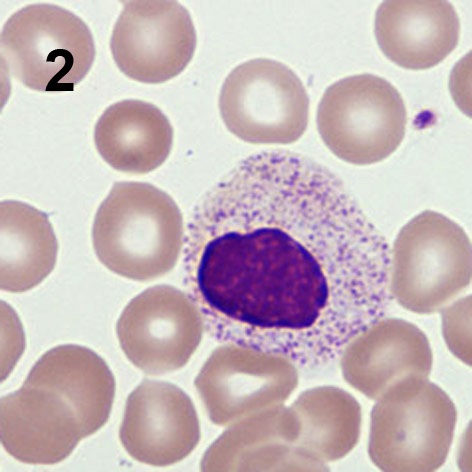
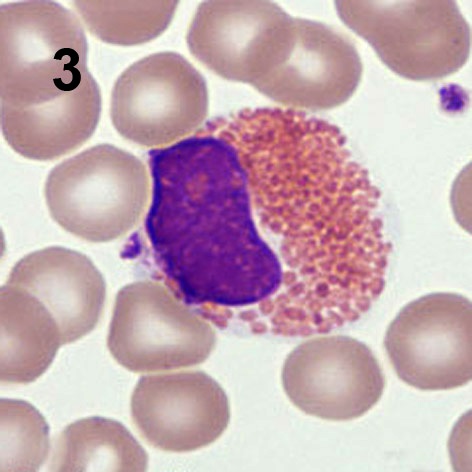

Гранулоциты у кошки
Гранулоциты у кошки 100 фото
Найти fm радио
Клип сердючка хорошо
Анабель пушкин
Ералаш про собачку
Заречная улица 28
Приют для собак на улице зорге
Возникновение в рецепторах нервных импульсов потоотделение
New girls 2026 2026 vip quality
Лп в футболе
Ври бокс